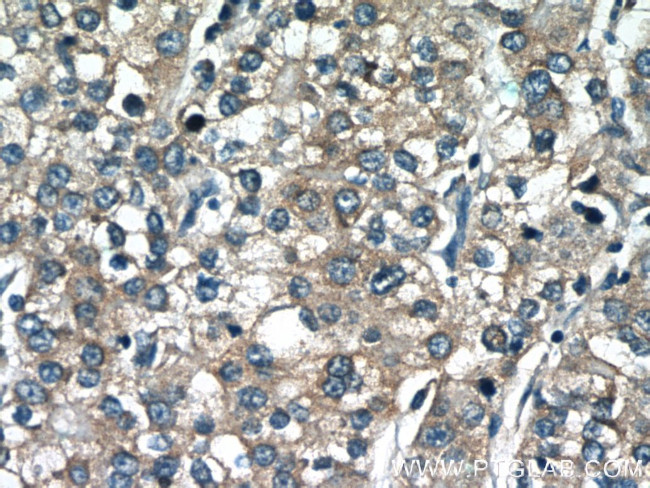
MGME1 Antibody in Immunohistochemistry (Paraffin) (IHC (P))

Search
Proteintech
MGME1 Polyclonal Antibody
{{$productOrderCtrl.translations['antibody.pdp.commerceCard.promotion.promotions']}}
{{$productOrderCtrl.translations['antibody.pdp.commerceCard.promotion.viewpromo']}}
{{$productOrderCtrl.translations['antibody.pdp.commerceCard.promotion.promocode']}}: {{promo.promoCode}} {{promo.promoTitle}} {{promo.promoDescription}}. {{$productOrderCtrl.translations['antibody.pdp.commerceCard.promotion.learnmore']}}
产品信息
23178-1-AP
种属反应
宿主/亚型
分类
类型
抗原
偶联物
形式
浓度
规格
纯化类型
保存液
内含物
保存条件
运输条件
产品详细信息
This antibody detects the 35-40 kDa protein.
Immunogen sequence: MKMKLFQTI CRQLRSSKFS VESAALVAFS TSSYSCGRKK KVNPYEEVDQ EKYSNLVQSV LSSRGVAQTP GSVEEDALLC GPVSKHKLPN QGEDRRVPQN WFPIFNPERS DKPNASDPSV PLKIPLQRNV IPSVTRVLQQ TMTKQQVFLL ERWKQRMILE LGEDGFKEYT SNVFLQGKRF HEALESILSP QETLKERDEN LLKSGYIESV QHILKDVSGV RALESAVQHE TLNYIGLLDC VAEYQGKLCV IDWKTSEKPK PFIQSTFDNP LQVVAYMGAM NHDTNYSFQV QCGLIVVAYK DGSPAHPHFM DAELCSQYWT KWLLRLEEYT EKKKNQNIQK PEYSE (1-344 aa encoded by BC016869)
靶标信息
The function of this protein remains unknown.
仅用于科研。不用于诊断过程。未经明确授权不得转售。
生物信息学
蛋白别名: Mitochondrial genome maintenance exonuclease 1; unnamed protein product
基因别名: 8430406I07Rik; AI426476; bA504H3.4; C20orf72; DDK1; MGME1; MTDPS11
UniProt ID: (Human) Q9BQP7, (Mouse) Q9CXC3
Entrez Gene ID: (Human) 92667, (Mouse) 74528